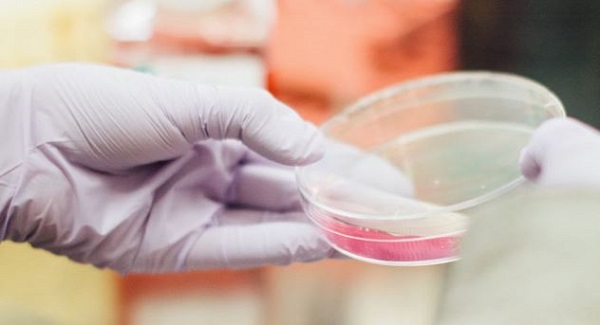

Clinical trial on schedule and $600,000 in R&D funding accessed: EMVision
Brain imaging technology company EMVision Medical Devices has given an update on progress of its clinical trial and a Medical Research Future Fund-backed R&D program, with the latter seeing the company access a $600,000 milestone payment. The clinical trials are in the pre-validation phase and running to schedule, according to a statement from EMVision on…